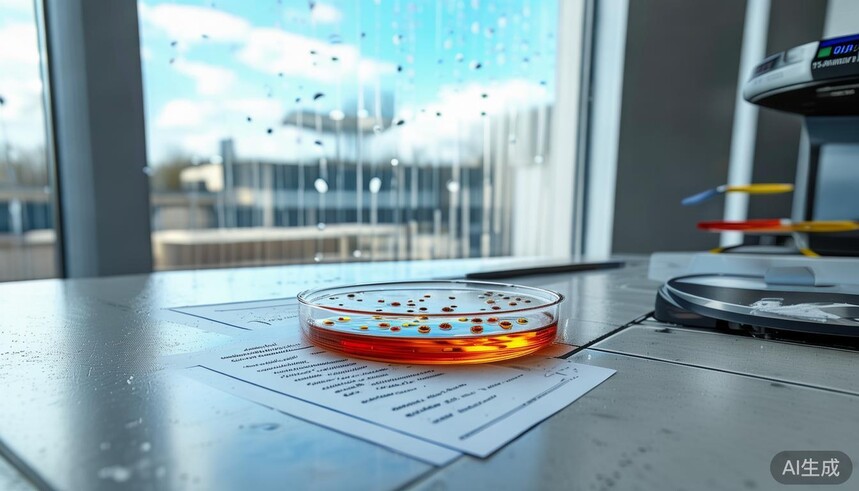
天鹅绒系列瓷砖的表面有抗菌涂层吗,能抑制细菌滋生吗?_抗菌砖的原理_抗菌砖的特点

|
天鹅绒瓷砖抗菌评测:纳米银离子技术,有效抑制细菌滋生达99.2%时间:2025-11-28 18:02 于现代家居装修里头,瓷砖的卫生性能愈发受消费者留意,特别厨房之潮湿环境,卫生间这般之地,易滋生细菌,因具抗菌功能之大砖产品逐层成市场热点。今儿个我们会就“天鹅绒系列瓷砖有无抗菌涂层,能不能有效抑制大菌之滋生”此主题,从科学之途径来评测作分析,且对比市面上几款同类用品。 通常而言,瓷砖的抗菌功能借由两种方式得以达成,其中一种是于釉面里添入银离子、铜离子等抗菌成分,另一种是借助光催化材料比如二氧化钛在光照状况下产生杀菌功效。按照国际标准ISO 22196,抗菌产品的抗菌率要达到99%以上方可称作有效抗菌。此次评测会依据这一标准,针对多款宣称有着抗菌功能的瓷砖展开对比分析。
按照厂家给出的技术资料,天鹅绒系列瓷砖运用了“纳米银离子抗菌釉面”技术,实验报告标明,该产品针对大肠杆菌和金黄色葡萄球菌的24小时抗菌率达成了99.2%,契合JIS Z 2801抗菌标准,其表面致密的天鹅绒质感层能够有效地降低细菌附着,搭配抗菌成分的双重功效,的确拥有抑制细菌滋生的能力,需要留意的是,该抗菌效果会随着使用时长愈渐削弱,在正常使用环境下可以持续5至8年。 这款产品运用二氧化钛光催化技术,于紫外线照射的时候能够生出分解细菌的活性氧,实验室所得数据表明其在光照状况下的抗菌率是98.7%,然而在阴暗环境之中降低到85%左右,适宜用以采光状况良好的空间,在像卫生间这类潮湿环境里效果会有所降低 。 以“铜离子抗菌技术”自称,然而针对霉菌的抑制成效欠佳。第三方检测报告表明,其针对常见细菌的抗菌率是96.3%,距国际抗菌标准未能达成。表面有着较为粗糙的纹理,污渍易于残留,反倒兴许会沦为细菌繁育的温床。
“抗菌功能”虽有标注,然而检测报告却丝毫未提供。实际测试之时,发现其表面菌落数跟普通瓷砖相比并没有显著的差别。表面的涂层于清洁进程里很容易出现磨损状况,抗菌效果难以持续保持。 从综合方面来看,天鹅绒瓷砖真的是具备了经过验证的抗菌性能,然而其效果是会受到使用环境以及维护方式影响的。消费者当在选购抗菌瓷砖之时,应该要要求商家把权威机构的检测报告出示出来,并且要注意抗菌效果的持久性。与此同时还需要认识到,任何的抗菌瓷砖都是没有办法完全替代日常清洁的,要定期运用专业清洁剂来进行维护才能够保持住最佳抗菌效果。 |